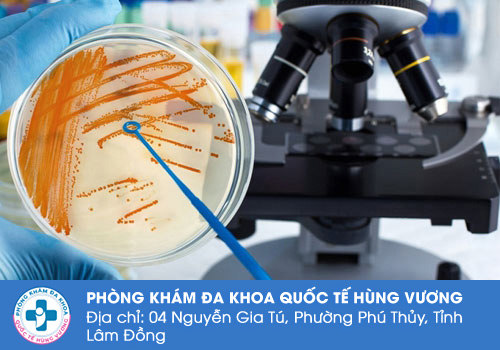

Công ty TNHH MTV dịch vụ y tế Quốc Tế Hùng Vương
4 Nguyễn Gia Tú, Phú Thuỷ, TP. Phan Thiết, Bình Thuận (đ/c cũ)
Liên lạc: 0252.7303.888
Bệnh lậu được nhắc đến là một căn bệnh tình dục đang khá phổ biến và có tỷ lệ nam giới mắc bệnh rất cao hiện nay. Căn bệnh này có thể làm ảnh hưởng đến sinh hoạt, sức khỏe và khả năng sinh sản của người mắc bệnh. Vậy nên việc chủ động phát hiện bệnh lậu sớm để điều trị là điều hết sức nên biết. Cùng chúng tôi tìm hiểu thời gian ủ bệnh lậu ở nam giới và mức độ nguy hiểm của căn bệnh này thông qua những chia sẻ dưới đây.
Bệnh lậu được đa số mọi người biết đến là căn bệnh truyền nhiễm chủ yếu, thông qua các hoạt động tình dục không an toàn. Căn bệnh này có khả năng gặp ở mọi đối tượng và không có sự phân biệt tuổi tác hay giới tính. Những đối tượng có đời sống tình dục phức tạp, quan hệ nhiều người hoặc quan hệ với gái mại dâm mà không sử dụng các biện pháp an toàn bảo vệ thì nguy cơ lây nhiễm bệnh rất cao.
Ngoài ra việc vô tình phải tiếp xúc với vết thương hở, dùng chung bơm kim tiêm, chất dịch nhầy có nguy cơ lây nhiễm lậu cầu. Bởi vì bên trong chất dịch hay máu của người bệnh là môi trường thuận lợi để cho vi khuẩn lậu cầu có cơ hội phát triển. Trong một số trường hợp phụ nữ mang thai Nếu mắc bệnh lậu cũng có thể lây nhiễm sang con. Ở trẻ sơ sinh mắc phải bệnh lậu sẽ gây ra những ảnh hưởng vô cùng nghiêm trọng.
Rất nhiều trường hợp nam giới đã bỏ qua thời gian ủ bệnh và đến khi bảy bước sang giai đoạn tiến triển nặng mới điều trị, Chính việc này đã bỏ qua giai đoạn vàng trong việc điều trị bệnh lậu và việc điều trị về sau sẽ có dứt điểm. Vậy nên cần phải xác định được thời gian ủ bệnh lậu ở nam giới để chủ động đi thăm khám và điều trị kịp thời.

Theo các chuyên gia y tế thì vi khuẩn lậu cầu khi xâm nhập vào bên trong cơ thể sẽ bắt đầu bước vào giai đoạn ủ bệnh. Thời gian ủ bệnh lậu ở nam giới còn phụ thuộc vào nhiều yếu tố khác nhau. Trong một số trường hợp bệnh lậu có thể có thời gian ủ bệnh ngắn và sẽ xuất hiện các triệu chứng đầu tiên sau 2 đến 5 ngày nhiễm bệnh. Tuy nhiên ở nhiều trường hợp thời gian ủ bệnh lậu có khả năng kéo dài hơn đến tận 14 ngày.
Như đã chia sẻ thì có rất nhiều các yếu tố sẽ tác động đến thời gian ủ bệnh của người nhiễm. Có những người có sức khỏe yếu hay thường xuyên dùng rượu bia chất kích thích thì thời gian ủ bệnh lậu sẽ ngắn hơn so với người bình thường. Trong một số trường hợp người bệnh sử dụng thuốc kháng sinh cũng có thể khiến bệnh lậu ở trạng thái ủ bệnh lâu hơn.
Nắm được các thông tin như thời gian ủ bệnh lậu ở nam giới thì chắc chắn bạn cũng không thể bỏ qua được những ảnh hưởng mà căn bệnh này gây đến cho người bệnh. Dưới đây là một số những ảnh hưởng nghiêm trọng mà bệnh lậu có thể gây ra cho nam giới:
Đa số nằm dưới khi biết bản thân mình bị mắc bệnh lậu đều có tâm lý hoang mang và lo lắng. Nam giới luôn phải sống trong nỗi mặc cảm bất an và lo nghĩ rằng mọi người xung quanh sẽ xa lánh và định kiến về họ. Những điều này sẽ khiến cho nam giới khó tập trung vào công việc, ảnh hưởng đến chất lượng cuộc sống.
Bệnh lậu cũng là căn bệnh có thể ảnh hưởng trực tiếp tới đời sống tình dục của nam giới. Khuẩn lậu có thể khiến cho nam giới xuất hiện tình trạng đau khi cương cứng dương vật, đau đớn khi quan hệ, và thậm chí khi xuất tinh có thể ra máu. Vì bệnh lậu là căn bệnh có thể lây lan qua đường tình dục nên nguy cơ cao lây nhiễm cho bạn tình. Khi mắc bệnh lậu thì việc tạm dừng quan hệ tình dục để điều trị là vô cùng cần thiết. Nhưng cũng vì vậy mà nam giới không thể thỏa mãn được rất ham muốn tình dục của bản thân mình cũng như bạn tình. Điều này tiếp diễn dài có thể gây mâu thuẫn trong mối quan hệ tình cảm.

Bệnh lậu phát triển mạnh mẽ và tấn công vào sâu trong các cơ quan của cơ thể có thể khiến cho nam giới mắc các bệnh lý nam khoa nguy hiểm như: Viêm bao quy đầu, hẹp niệu đạo, viêm tuyến tiền liệt, vô sinh - hiếm muộn,... Ngoài ra quản lộ có thể phát triển mạnh mẽ và Lan sang nhiều cơ quan khác gây ra các vấn đề sức khỏe như viêm gan, đau khớp, viêm van tim hay tổn thương não bộ,...
Nếu như nam giới chủ quan không điều trị bệnh lậu kịp thời thì lậu khuẩn có khả năng xâm nhập vào đường máu và gây ra hiện tượng nhiễm trùng. Một số biểu hiện của việc nam giới bị nhiễm trùng máu có thể kể đến như ra mồ hôi nhiều huyết áp tụt thân nhiệt thay đổi thất thường sốt cao ớn lạnh tim đập nhanh,...
Bệnh lậu là căn bệnh nguy hiểm càng để bệnh lâu không điều trị càng gây ra những biến chứng khôn lường. Vậy nên xác định được thời gian ủ bệnh lậu ở nam giới và nghi ngờ mình có khả năng bị phơi nhiễm căn bệnh này thì nên chủ động tìm kiếm cơ sở chuyên khoa để được bác sĩ thăm khám cho làm xét nghiệm và sớm có phương án điều trị. Nếu bạn còn phân vân chưa biết lựa chọn cơ sở nào thì hãy trực tiếp đến với địa chỉ Phòng Khám Đa Khoa Quốc Tế Hùng Vương ở 4 Nguyễn Gia Tú, P. Phú Thuỷ, Tỉnh Lâm Đồng để thăm khám và điều trị với những yếu tố chất lượng như sau:
► Phòng khám là cơ sở tư nhân hội tụ đầy đủ các bác sĩ giỏi chuyên môn trong lĩnh vực sức khỏe bệnh xã hội, đã từng xét nghiệm và điều trị cho rất nhiều trường hợp nam giới bị mắc bệnh lậu.
► Bệnh nhân sẽ luôn có sự đồng hành hỗ trợ từ phía nhân viên y tế trong các thủ tục giấy tờ và được hướng dẫn quy trình thăm khám rõ ràng.
► Các phương pháp để xét nghiệm và điều trị bệnh lậu hay các bệnh xã hội khác đều hiện đại, tiếp cận đến công nghệ y học tiên tiến trên thế giới.
► Mọi thông tin cá nhân của bệnh nhân sẽ được phòng khám bảo mật và khi bệnh nhân điều trị sẽ được đưa vào không gian phòng bệnh riêng.
► Bệnh nhân có thể liên hệ trước đến nhân viên y tế để đặt lịch khám và có thể liên hệ đến hệ thống tư vấn trực tuyến khi cần hỗ trợ.
Những thông tin trên đây của chúng tôi hẳn đã giúp cho nhiều bạn giải đáp được thắc mắc về thời gian ủ bệnh lậu ở nam giới và các biến chứng của căn bệnh này. Nếu cần hỗ trợ thêm các thông tin liên quan thì nam giới hãy liên lạc sớm đến số hotline 0252.7303.888 hoặc nhắn tin vào khung chat để được tư vấn viên giúp đỡ nhé.
Đặt lịch hẹn thăm khám trên KHUNG TƯ VẤN online để ĐƯỢC hưởng ưu đãi:
Phòng Khám Đa Khoa Quốc Tế Hùng Vương địa chỉ: 4 Nguyễn Gia Tú, P. Phú Thuỷ, Tỉnh Lâm Đồng
- Đặt lịch hẹn qua số điện thoại: 0252.7303.888 để được đăng ký khám sớm không mất công chờ đợi.
- Đăng ký ngay để nhận tư vấn và dịch vụ ưu đãi: